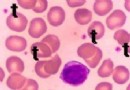

什麼是鵝口瘡?如何預防和防治
鵝口瘡是新生兒時期經常見到的疾病,尤其是出生一周以後的早產兒。俗稱“白口糊”,中醫叫“雪口症”。是由白色念珠菌感染引起的,是屬於真菌的一種,也稱霉菌。一般認為是由於新生兒免疫機能低下,如虛弱,營養不良,腹瀉,或因感染而長期應用各種抗生素或激素如強的松等所造成的。

有了鵝口瘡的寶寶常表現為寶寶嘴巴裡有很多像奶斑一樣的東西粘在口腔壁上,與新生兒吃奶留下的奶很難區別。如果用棉簽能擦掉則為奶斑,擦不掉則為鵝口瘡了。到醫院裡請醫生把這些白色的物質取下來做真菌直接塗片檢查,還可以看到菌絲和成群芽孢呢。如果不及時治療,斑點狀霉菌會越長越多,可融合成片或連在一起,且厚度增加。不嚴重時新生兒無特殊不適,隨著病情加重,新生兒可表現出煩躁不安,進食減少,且因進食時疼痛而拒食。嚴重的可擴散到咽喉,引起吞咽困難;若擴散到氣管可引起霉菌性腸炎和霉菌性肺炎,甚至全身性念珠菌感染。
那麼怎樣預防和如何治療鵝口瘡呢?
先看看這些引起鵝口瘡的念珠菌是怎麼來的吧。這些肉眼看不見的霉菌主要來自產婦陰道、帶菌的醫護人員以及沒有經過嚴格消毒的奶瓶和尿布。寶寶的皮膚或口腔粘膜接觸到這些被霉菌污染過的東西後就會引起局部的感染。所以剛做母親的產婦,和嬰兒室醫護人員應該注意個人衛生,母親喂奶前應該洗手並用溫水擦干淨自己的奶頭,醫護人員每次接觸孩子以前也要把自己的手洗干淨;每次用奶瓶前要經過沸水消毒。當發現寶寶的口腔裡長出白色絮狀物時,有的老人喜歡用手或布擦洗口腔,這樣做是徒勞的,白斑過幾天又會重新長出來。即使表面上擦掉了仍然有許多霉菌存在,到了一定時候又繁殖起來。由於弱鹼環境不利於霉菌生長,故可用2%-5%的蘇打水清洗口腔。其他方法如1%甘油或中藥冰硼散塗口腔均有療效。最有效的方法是,用每毫升含制霉菌素5~10萬單位的液體塗局部,每天3次即可,塗藥時不要吃奶或喝水,最好在吃奶以後塗藥,以免沖掉口腔中的藥物。在使用任何藥物前都要到醫生處咨詢。
- 上一頁:鵝口瘡的護理方法
- 下一頁:防治嬰兒鵝口瘡的技巧
- 新生兒疾病
-
18個月的寶寶每天應睡多長時間?
18個月的寶寶每天應睡多長時
-
小兒夢多
健康咨詢描述:
-
小測試了解你的壓抑程度(1)
你是不是經常會無緣無故地對孩子和家人發火?哪怕孩子犯的錯非常小
-
補鈣鐵問題
補鈣鐵問題